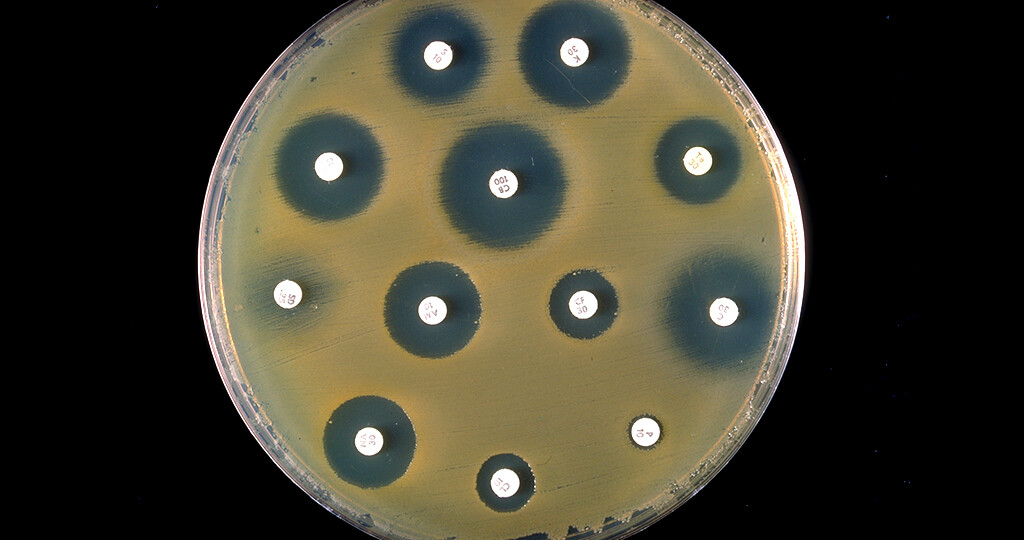

Wie Lange Dauert Es Bis Antibiotika Wirken
Wie lange dauert es bis antibiotika wirken. Liegt eine bakterielle Blasenentzündung bei Ihrer Katze vor ist die Dauer normalerweise einige Tage. Viele Faktoren beeinflussen die Dauer wie lange das Antibiotikum tatsächlich noch im Körper ist. Nehme jetzt seit Donnerstag Antibiotika und anstatt Besserung ist es noch etwas schlimmer geworden.
Dann kannst Du sicher sein dass es gegen Deine Erkrankung wirksam ist. Doch in der Regel wirken Antibiotika 6 bis 12 Stunden nach. Es kann bis zu 24 Stunden dauern bis sich der Arzt besser fühlt wenn er das richtige Antibiotikum für Ihre Krankheit verschrieben hat.
Nehmen Sie Ihr Antibiotikum zeitgerecht ein und die Packung auf jeden Fall aus. Probiotika brauchen in der Regel zwischen einigen Tagen und mehreren Wochen bis sie wirken. Die Bioverfügbarkeit beträgt 50 bis 70.
Manchmal verkrampfe ich mich auch extrem beim schlucken weils so weh tut. Antibiotika beginnen sofort nach Beginn der Einnahme zu wirken. Warum Ihr Probiotikum möglicherweise nicht wirkt oder länger braucht um zu wirken Probiotika wirken nicht bei jedem.
Dies gilt für den Großteil der Antibiotika die uns der Arzt verschreibt. Je nachdem wofür Sie Probiotika einnehmen können sich die Symptome zwischen einigen Tagen und einigen Monaten bessern. 6 bis 12 Stunden wirkt Antibiotika im Körper nach.
Wie lange wirken Antibiotika im Körper nach. Dies gilt für den Großteil der Antibiotika die uns der Arzt verschreibt. Einfache Frage schwierige Antwort.
Und manchmal tun sie vielleicht gar nichts. Wählen Sie eine oder mehrere Sorten aus die nachweislich Ihre spezifischen Symptome verbessern oder die allgemeine Gesundheit verbessern.
Spätestens nach 72 Stunden solltest Du eine Besserung der Symptome feststellen.
Wählen Sie eine oder mehrere Sorten aus die nachweislich Ihre spezifischen Symptome verbessern oder die allgemeine Gesundheit verbessern. Je nachdem wofür Sie Probiotika einnehmen können sich die Symptome zwischen einigen Tagen und einigen Monaten bessern. 6 bis 12 Stunden wirkt Antibiotika im Körper nach. Viele Faktoren beeinflussen wie schnell der Körper Antibiotika verarbeiten kann. Wie schnell es Ihnen nach einer Antibiotikabehandlung besser geht ist unterschiedlich. ACC akut ist ganz gut und gibt es als Brausetablette. Wie lange dauert es bis Antibiotika wirken. Eine Antibiotikatherapie schlägt bei Katzen in der Regel sehr schnell an. Nehme jetzt seit Donnerstag Antibiotika und anstatt Besserung ist es noch etwas schlimmer geworden.
Besserung zeigt sich nach wenigen Tagen 2-3 aber wichtig ist dass du das Antibiotikum fertig nimmst solange wies der Arzt verordnet hat. Bei der einmal täglichen Einnahme an den darauffolgenden Tagen immer zur selben Uhrzeit Bei der 2-mal täglichen Einnahme im Abstand von 12 Stunden Bei der 3-mal täglichen Einnahme im Abstand von 8 Stunden. Wie lange wirken Antibiotika im Körper nach. Es kann bis zu 24 Stunden dauern bis sich der Arzt besser fühlt wenn er das richtige Antibiotikum für Ihre Krankheit verschrieben hat. Je nachdem wofür Sie Probiotika einnehmen können sich die Symptome zwischen einigen Tagen und einigen Monaten bessern. Je nach Empfänglichkeit des. 6 bis 12 Stunden wirkt Antibiotika im Körper nach.

Post a Comment for "Wie Lange Dauert Es Bis Antibiotika Wirken"